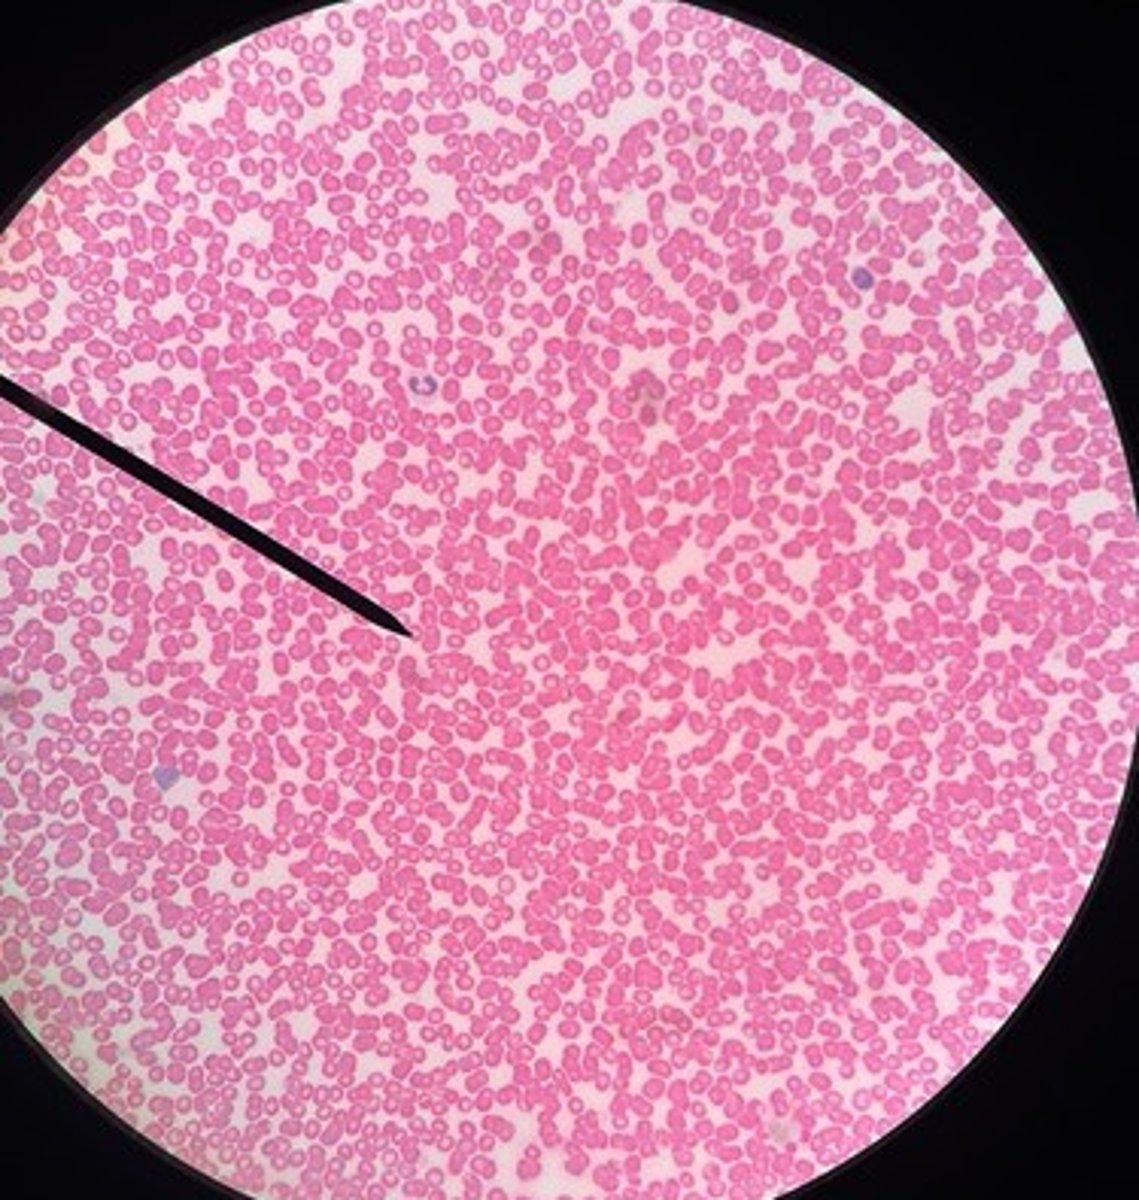

BIO203 a&p LAB- tissue slides
0.0(0)
0.0(0)
New
Card Sorting
1/10
There's no tags or description
Looks like no tags are added yet.
Study Analytics
Name | Mastery | Learn | Test | Matching | Spaced |
|---|
No study sessions yet.
11 Terms
1
New cards
bone

2
New cards
cartilage (lung)

3
New cards
red blood cells
4
New cards
dense regular (tendon)

5
New cards
areolar

6
New cards
simple cuboidal (kidney tubule)

7
New cards
pseudostratified (trachea)

8
New cards
stratified squamous (skin)

9
New cards
skeletal muscle

10
New cards
examples of epithelial tissue
stratified squamous, simple cuboidal, pseudostratified
11
New cards
examples of connective tissue
hyaline cartilage, dense regular, areolar, blood, bone